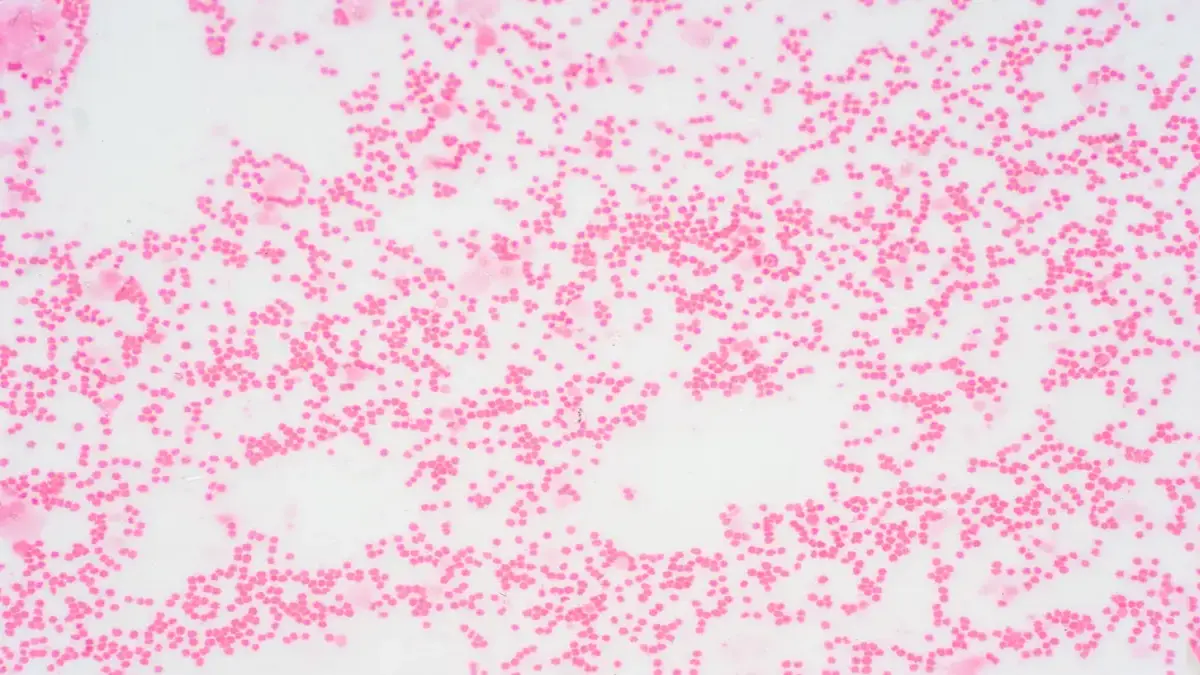
Mikroskopische Aufnahme von Zellen, die für die Diagnostik und Therapie von Myelofibrose und Anämie relevant sind.

Die neusten Beiträge

Sutimlimab verbessert Lebensqualität bei Kälteagglutinin-Krankheit
Leitlinien-Update: Momelotinib bei Myelofibrose und Anämie empfohlen

Versorgungsnahe Daten aus dem deutschen ITP-Register

Differenzialdiagnose: Kutanes Lymphom

Bei blastozytoider plasmacytoider dendritischer Zellneoplasie (BPDCN) hilft eine neuartige Therapie

CHIP spielt auch bei soliden Tumoren eine Rolle

Senken GLP-1-Agonisten das Krebsrisiko?

🔒 PNH: Einsatz von Iptacopan im Versorgungsalltag angekommen

PNH: Neue Therapieansätze
